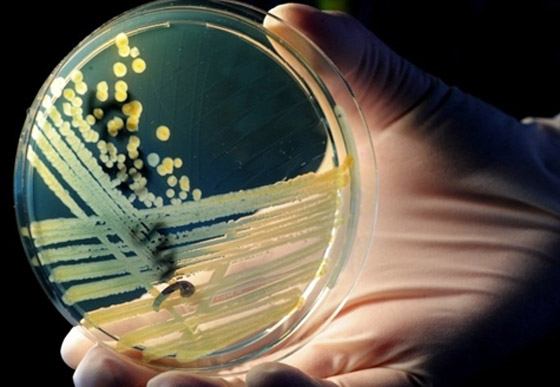
بكتيريا من نوع E.coli تنتشر بشكل خطير وتسبب وفيات
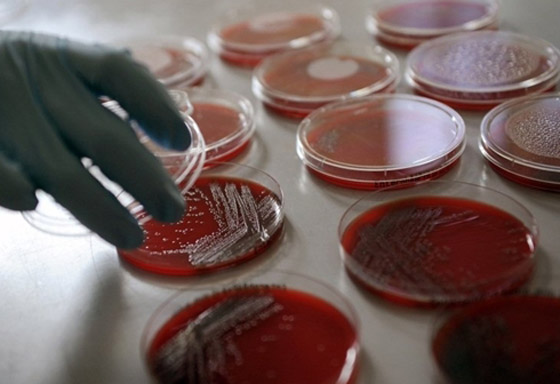
بكتيريا من نوع E.coli تنتشر بشكل خطير وتسبب وفيات
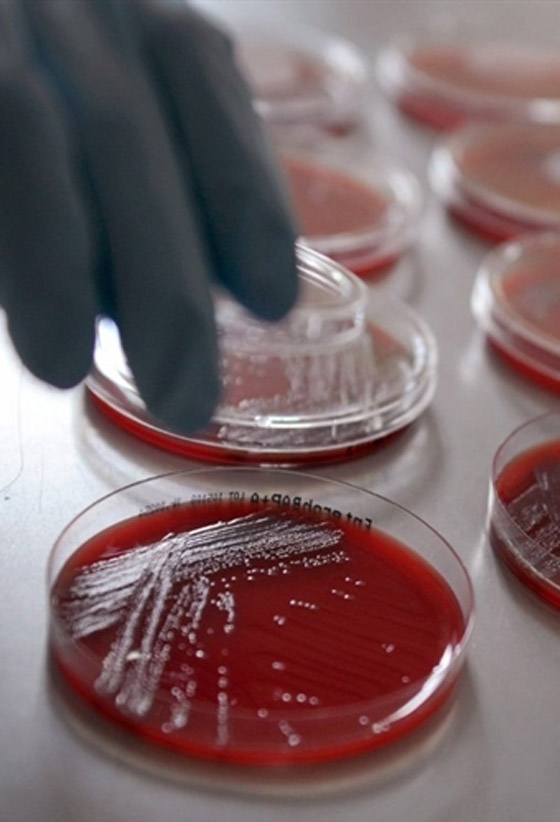
بكتيريا من نوع E.coli تنتشر بشكل خطير وتسبب وفيات

الامراض تزداد والعلم يتطور أكثر ويجد طرق وحلول لعلاج الأمراض، فقد حذرت مؤخرا السلطات الصحية الالمانية من انتشار سريع لبكتيريا تسبب التهابات في الجهاز الهضمي وقد تنتج عنها وفيات عدة، فيما يبدو انها ادت بالفعل الى وفاة ثلاثة اشخاص في شمال البلاد. وصرح رئيس معهد روبرت كوخ الفدرالي المكلف بمراقبة الامراض ومكافحتها راينهارت بورغر "علينا ان نقول بوضوح اننا نتوقع وفيات".
|
|
|
ثلاثة اشخاص قضوا نحبهم بسبب |
ويحتمل ان ثلاثة اشخاص قضوا نحبهم بسبب عدوى بكتيريا ايكولاي المثيرة للالتهابات الداخلية والتي طالت حتى الان شمال المانيا ولا سيما هامبورغ. لكن سجلت حالات اصابة في ولايات اخرى بحسب بورغر. واعرب بورغر عن قلقه لان اغلبية المرضى بالغون فيما اعتاد هذا المرض استهداف الاطفال الصغار.
وتنتقل بكتيريا ايكولاي عبر تناول اغذية ملوثة على غرار اللحوم النيئة او غير المطبوخة جيدا والحليب الطازج. ومن اعراض الاصابة الاسهال والدم في البراز والام الرأس واوجاع حادة في المعدة. لكن تعذر حتى الان تحديد مصدر العدوى الجارية التي لم يستبعد معهد روبرت كوخ "ان تكون فاعلة حتى الان".

imagebank - AFP